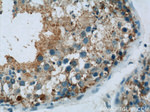
UBQLN2 Antibody in Immunohistochemistry (Paraffin) (IHC (P))

Search
Proteintech
UBQLN2 Polyclonal Antibody
{{$productOrderCtrl.translations['antibody.pdp.commerceCard.promotion.promotions']}}
{{$productOrderCtrl.translations['antibody.pdp.commerceCard.promotion.viewpromo']}}
{{$productOrderCtrl.translations['antibody.pdp.commerceCard.promotion.promocode']}}: {{promo.promoCode}} {{promo.promoTitle}} {{promo.promoDescription}}. {{$productOrderCtrl.translations['antibody.pdp.commerceCard.promotion.learnmore']}}
产品信息
23449-1-AP
种属反应
宿主/亚型
分类
类型
抗原
偶联物
形式
浓度
规格
纯化类型
保存液
内含物
保存条件
运输条件
产品详细信息
Immunogen sequence: MAENGESSG PPRPSRGPAA AQGSAAAPAE PKIIKVTVKT PKEKEEFAVP ENSSVQQFKE AISKRFKSQT DQLVLIFAGK ILKDQDTLIQ HGIHDGLTVH LVIKSQNRPQ GQSTQPSNAA GTNTTSASTP RSNSTPISTN SNPFGLGSLG GLAGLSSLGL SSTNFSELQS QMQQQLMASP EMMIQIMENP FVQSMLSNPD LMRQLIMANP QMQQLIQRNP EISHLLNNPD IMRQTLEIAR NPAMMQEMMR NQDLALSNLE SIPGGYNALR RMYTDIQEPM LNAAQEQFGG NPFASVGSSS SSGEGTQPSR TENRDPLPNP WAPPPATQSS ATTSTTTSTG SGSGNSSSNA TGNTVAAANY VASIFSTPGM QSLLQQITEN PQLIQNMLSA PYMRSMMQSL SQNPDLAAQM MLNSPLFTAN PQLQEQMRPQ LPAFLQQMQN PDTLSAMSNP RAMQALMQIQ QGLQTLATEA PGLIPSFTPG VGVGVLGTAI GPVGPVTPIG PIGPIVPFTP IGPIGPIGPT GPAAPPGSTG SGGPTGPTVS SAAPSETTSP TSESGPNQQF IQQMVQALAG ANAPQLPNPE VRFQQQLEQL NAMGFLNREA NLQALIATGG DINAAIERLL GSQPS (1-624 aa encoded by BC069237)
靶标信息
This gene encodes an ubiquitin-like protein (ubiquilin) that shares high degree of similarity with related products in yeast, rat and frog. Ubiquilins contain a N-terminal ubiquitin-like domain and a C-terminal ubiquitin-associated domain. They physically associate with both proteasomes and ubiquitin ligases; and thus, are thought to functionally link the ubiquitination machinery to the proteasome to affect in vivo protein degradation. This ubiquilin has also been shown to bind the ATPase domain of the Hsp70-like Stch protein.
仅用于科研。不用于诊断过程。未经明确授权不得转售。
生物信息学
蛋白别名: Chap1; DSK2 homolog; HRIHFB2157; Nedd4 binding protein 4; PLIC-2; Protein linking IAP with cytoskeleton 2; Ubiquilin-2; Ubiquitin-like product Chap1/Dsk2; ubiquitin-like type II; unnamed protein product
基因别名: ALS15; CHAP1; DSK2; HRIHFB2157; N4BP4; PLIC2; RGD1563566; UBQLN2
UniProt ID: (Human) Q9UHD9
Entrez Gene ID: (Human) 29978, (Rat) 317396